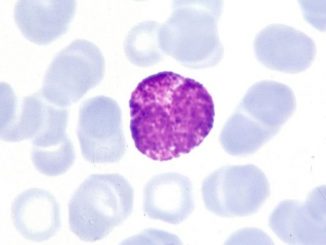

Krvna slika: Povišeni eozinofili u krvi (eozinofilija)
Eozinofili su vrsta belih krvnih zrnaca. Bela krvna zrnca štite organizam od raznih oboljenja i infekcija. Eozinofili pomažu u zaštiti organizma od bolesti i infekcija […]

Eozinofili su vrsta belih krvnih zrnaca. Bela krvna zrnca štite organizam od raznih oboljenja i infekcija. Eozinofili pomažu u zaštiti organizma od bolesti i infekcija […]

Kao jedan od dvanaest faktora odgovornih za zgrušavanje krvi, fibrinogen je veoma važan za proces oporavka organizma, što mi često uzimamo zdravo za gotovo. Povišen […]

MONOCITI su veliki leukociti koji se prave u koštanoj srži i putuju putem krvi do tkiva različitih organa. Njihova glavna funkcija je uklanjanje ćelijskog otpada […]

KETONI U URINU se mogu javiti kod osoba koje praktikuju visokoproteinsku keto dijetu ili zbog nekoh oboljenja.Najvažnija stvar u ovom tekstu jeste kontekst. Za osobe […]

SAZNAJTE KAKO POVEĆATI LEUKOCITE U KRVI prirodnim putem i ishranom… Nizak broj leukocita (bela krvna zrnca) se može javiti zbog mnoštva oboljenja, tako da je […]

ŠTA SU GRANULOCITI? Granulociti (GRA) su bele krvne ćelije (leukociti) koje pomažu imunološkom sistemu da se izbori protiv infekcije. Oni imaju karakterističnu morfologiju: imaju velike […]

PROTROMBINSKO VREME (PV/PT) je najčešće korišćen koagulacijski test kojim se meri brzina zgrušavanja krvi. Protrombinsko vreme je analiza krvi koja može da se koristi za […]
ŠTA SU BAZOFILNI GRANULOCITI? Bazofilni granulociti ili bazofili su bele krvne ćelije, koje su najmanje zastupljene u perifernoj krvi i pripadaju kategoriji granulocita. Slično kao […]

EPITELNE ĆELIJE U URINU predstavljaju dijagnostički nalaz, do koga se dolazi tokom urinalize i mogu da predstavljaju znak upozorenja za lekara, pošto ukazuju na nekoliko […]

SLUZ U MOKRAĆI je obično tečna i transparentna. Ponekad daje mokraći zamućen i beličast izgled. Ako je mokraća samo beličasta, možda je reč o normalnoj […]
Copyright © 2026 | WordPress Theme by MH Themes